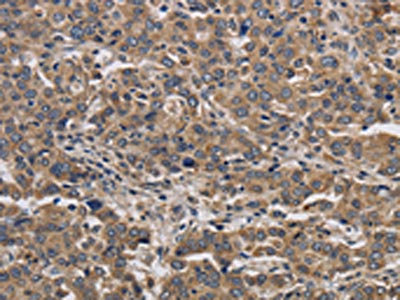

KIF22 Antibody
-
中文名稱:KIF22兔多克隆抗體
-
貨號:CSB-PA968068
-
規格:¥1100
-
圖片:
-
The image on the left is immunohistochemistry of paraffin-embedded Human colon cancer tissue using CSB-PA968068(KIF22 Antibody) at dilution 1/40, on the right is treated with synthetic peptide. (Original magnification: ×200)
-
The image on the left is immunohistochemistry of paraffin-embedded Human liver cancer tissue using CSB-PA968068(KIF22 Antibody) at dilution 1/40, on the right is treated with synthetic peptide. (Original magnification: ×200)
-
-
其他:
產品詳情
-
Uniprot No.:
-
基因名:KIF22
-
別名:A 328A3.2 antibody; KID antibody; KIF 22 antibody; kif22 antibody; KIF22_HUMAN antibody; Kinesin family member 22 antibody; Kinesin like 4 antibody; Kinesin like DNA binding protein antibody; Kinesin like DNA binding protein pseudogene antibody; Kinesin like protein 4 antibody; Kinesin like protein KIF22 antibody; Kinesin-like DNA-binding protein antibody; Kinesin-like protein 4 antibody; Kinesin-like protein KIF22 antibody; KNSL 4 antibody; KNSL4 antibody; OBP 1 antibody; OBP 2 antibody; OBP antibody; OBP1 antibody; OBP2 antibody; Origin of plasmid DNA replication binding protein antibody; OriP binding protein antibody; OTTHUMP00000123406 antibody; SEMDJL2 antibody
-
宿主:Rabbit
-
反應種屬:Human
-
免疫原:Synthetic peptide of Human KIF22
-
免疫原種屬:Homo sapiens (Human)
-
標記方式:Non-conjugated
-
抗體亞型:IgG
-
純化方式:Antigen affinity purification
-
濃度:It differs from different batches. Please contact us to confirm it.
-
保存緩沖液:-20°C, pH7.4 PBS, 0.05% NaN3, 40% Glycerol
-
產品提供形式:Liquid
-
應用范圍:ELISA,IHC
-
推薦稀釋比:
Application Recommended Dilution ELISA 1:2000-1:10000 IHC 1:50-1:200 -
Protocols:
-
儲存條件:Upon receipt, store at -20°C or -80°C. Avoid repeated freeze.
-
貨期:Basically, we can dispatch the products out in 1-3 working days after receiving your orders. Delivery time maybe differs from different purchasing way or location, please kindly consult your local distributors for specific delivery time.
-
用途:For Research Use Only. Not for use in diagnostic or therapeutic procedures.
相關產品
靶點詳情
-
功能:Kinesin family member that is involved in spindle formation and the movements of chromosomes during mitosis and meiosis. Binds to microtubules and to DNA. Plays a role in congression of laterally attached chromosomes in NDC80-depleted cells.
-
基因功能參考文獻:
- Chromokinesin Kid and kinetochore kinesin CENP-E differentially support chromosome congression without end-on attachment to microtubules. PMID: 25743205
- we conclude that inhibition of KIF22 suppresses cancer cell proliferation by delaying mitotic exit through the transcriptional upregulation of CDC25C. PMID: 24626146
- Whole-exome sequencing identifies mutations of KIF22 in spondyloepimetaphyseal dysplasia with joint laxity, leptodactylic type PMID: 22152677
- Recurrent dominant mutations affecting two adjacent residues in the motor domain of the monomeric kinesin KIF22 result in skeletal dysplasia and joint laxity PMID: 22152678
- in all breast tumor tissues analyzed, variations in the Kid/KIF22 mRNA levels mirrored those seen with SIAH-1 mRNAs. PMID: 20144232
- These results are consistent with Kid having a role in chromosome congression in vivo, where it would be responsible for the polar ejection forces acting on the chromosome arms. PMID: 12606572
- its molecular structure and interaction with microtubules PMID: 12692123
- These results suggest that distinct from its role in chromosome movement, Kid contributes to spindle morphogenesis by mediating spindle microtubules stabilization. PMID: 16176979
- human Aurora B and Kid are identified as APC/C(Cdh1) substrates PMID: 17726374
- Association of importin-beta and -alpha with hKid triggers the initial targeting of hKid to mitotic chromosomes; local Ran-GTP-mediated cargo release promotes the accumulation of hKid on chromosomes. PMID: 18268099
- These data suggest that Kid-mediated anaphase/telophase chromosome compaction prevents formation of multinucleated cells. PMID: 18329364
顯示更多
收起更多
-
相關疾病:Spondyloepimetaphyseal dysplasia with joint laxity, 2 (SEMDJL2)
-
亞細胞定位:Nucleus. Cytoplasm, cytoskeleton.
-
蛋白家族:TRAFAC class myosin-kinesin ATPase superfamily, Kinesin family
-
組織特異性:Expressed in bone, cartilage, joint capsule, ligament, skin, and primary cultured chondrocytes.
-
數據庫鏈接:
Most popular with customers
-
-
YWHAB Recombinant Monoclonal Antibody
Applications: ELISA, WB, IHC, IF, FC
Species Reactivity: Human, Mouse, Rat
-
Phospho-YAP1 (S127) Recombinant Monoclonal Antibody
Applications: ELISA, WB, IHC
Species Reactivity: Human
-
-
-
-
-